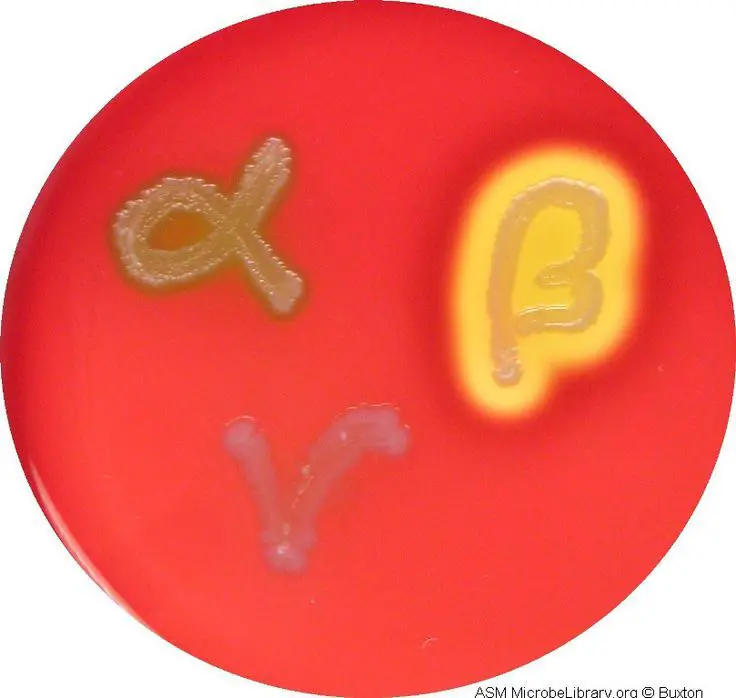

MCB LAB Exam 4 Vocab
1/27
There's no tags or description
Looks like no tags are added yet.
Name | Mastery | Learn | Test | Matching | Spaced |
|---|
No study sessions yet.
28 Terms
General purpose media
Media that has a wide variety of fuel supplies available & supports growth of most types of bacteria
Enriched media
Media that has been supplemented with highly nutritious materials
Selective media
Media that incorporates chemical substances that inhibit the growth of 1 type of bacteria while permitting the growth of another
Differential media
Media that incorporates chemical compounds that produce characteristic changes in appearance of bacterial colonies
Alpha hemolysis
Shows a green / brown color in medium
Partial hemolysis of RBCs

Beta hemolysis
Area appears yellow / transparent
Clear halo around colony
Complete hemolysis of RBCs

Gamma hemolysis
Does not break down RBCs
Leaves RBCs intact
Red color stays unchanged
No color change on agar plate
Hemolysins
Toxins produced by bacteria to destroy RBCs
Streptolysins
Hemolysins produced by Streptococci
Inhibitor
Substance that prohibits growth of organisms (i.e. dyes, antibiotics, salts)
Indicators
Color changes due to change in pH or presence of certain
byproducts of the organism’s metabolismUsed to identify bacteria
Staphylococcus Aureus
Most pathogenic of Staphylococci
Mannitol fermenter
Staphylococcus Epidermis
Non-disease causing Staphylococci
Grows but doesn’t change color of Mannitol Salt Agar
S. pyogens
Bacteria that will cause beta-hemolysis on a blood plate
Causes strep throat
S. pneumoniae
Bacteria that will cause alpha-hemolysis on a blood plate
E. faecalis
Bacteria that will cause gamma-hemolysis on a blood plate
Osmotic Pressure
Amount of force applied to a solution that prevents solvent from moving across a semipermeable membrane
Isotonic solution
Solution that’s equal in solute concentration to the cell
Water moves in & out of the cell at a similar rate
Same osmotic pressure
Hypotonic solution
Solution with lower solute concentration compared to cell
Water moves into the cell where the concentration is higher
Low osmotic pressure
Hypertonic solution
Solution with higher solute concentration compared to cell
Water leaves the cell toward higher concentration environment
High osmotic pressure
pH
Degree of acidity or alkalinity of a solution
Obligate anaerobes
Microorganisms that lack enzymes for processing toxic oxygen & die in its presence
Obligate aerobe
Microorganism that can’t grow without oxygen
Microaerophiles
Microbes that are harmed by normal atmospheric concentrations of oxygen but require a small amount of it in metabolism
Facultative anaerobes
Microbes that don’t require oxygen for metabolism but use it when present
Can grow anaerobically
Aerotolerant anaerobes
Microbes that don’t use oxygen but can survive & grow to a limited extent in its presence
Fluid thioglycolate medium
Liquid medium that can be used to support the growth of aerobic & anaerobic organisms
Catalase
Enzyme that detoxifies reactive oxygen species
Converts hydrogen peroxide into water & oxygen